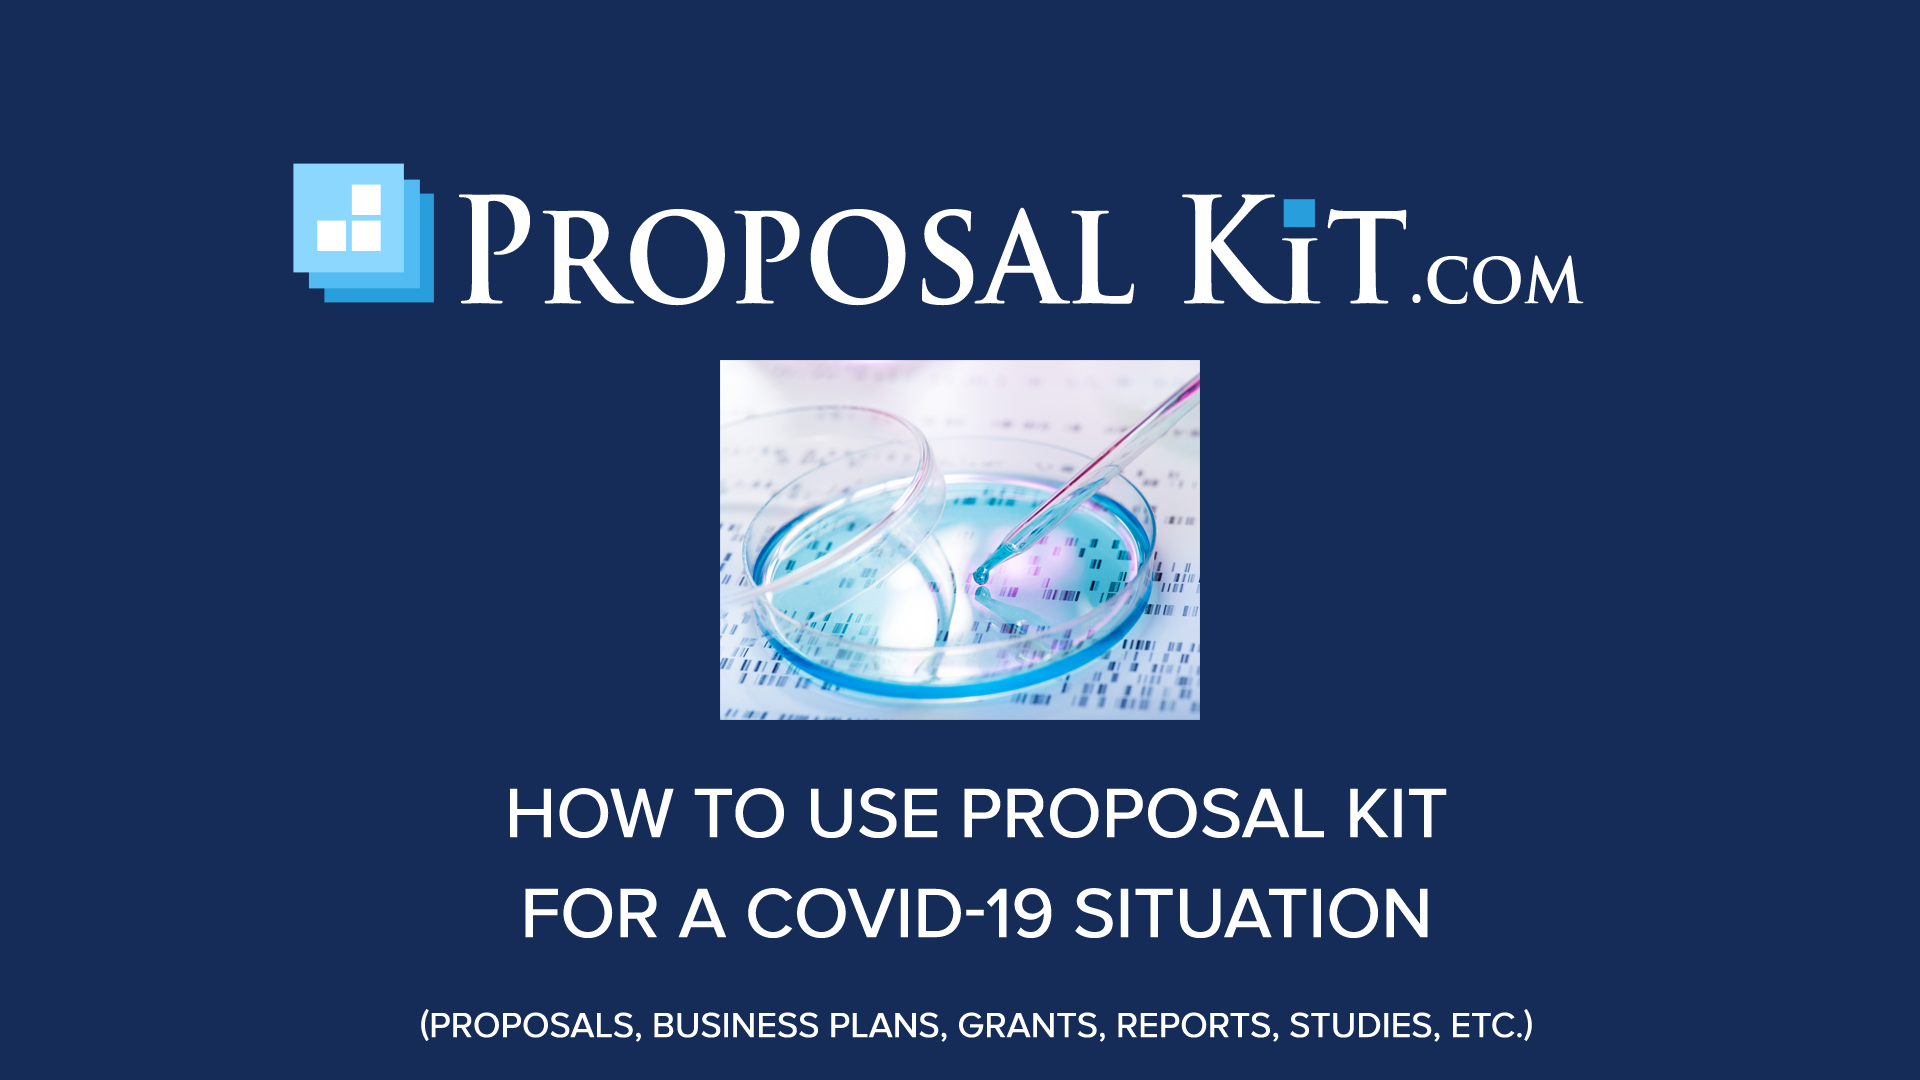
Covid 19 Related Proposal Writing Support

Contoh Penutup Proposal Covid 19 - Surat pribadi juga disebut dengan surat prive. Kepala bagian Personalia The Blitz Jl. Proposal kegiatan magang oleh.
Contoh penutup proposal covid 19. Ini contoh pesan WA yang beretika versi UI. Putri damayanti c 125030218113015 maela alfa fauza 125030218113019 siti ulfaniza a 125030218113036 rindy hartanti s 125030218113037 konsentrasi manajemen keuangan jurusan administrasi bisnis fakultas ilmu administrasi universitas brawijaya malang 2015 —– proposal kegiatan magang pada pt platinum ceramics industry. Ini Sebaran 8054 Kasus Baru. Surat dinas adalah salah satu media komunikasi tertulis yang digunakan untuk menyampaikan suatu informasi tentang kedinasan dibuat oleh lembaga.
 Contoh Proposal Pengajuan Dana Yang Baik Dan Benar Akseleran Blog From akseleran.co.id
Contoh Proposal Pengajuan Dana Yang Baik Dan Benar Akseleran Blog From akseleran.co.id
Penutup Demikian proposal kegiatan ini kami buat semoga dapat menjadi gambaran atas rencana kegiatan Perayaan Hari Kemerdekaan ke-74 Republik Indonesia 17 Agustus 2019. Contoh dan Cara Membuat Surat Dinas Sumber Gambar. Pada contoh teks berjudul Kiat Berwawancara Kerja pendahuluan yang dimaksud berupa pengertian wawancara dan manfaat bagi suatu perusahaan paragraf 1. Biasanya proposal penelitian berisi antara 2000 hingga 3500 kata 4-7 halaman. Putri damayanti c 125030218113015 maela alfa fauza 125030218113019 siti ulfaniza a 125030218113036 rindy hartanti s 125030218113037 konsentrasi manajemen keuangan jurusan administrasi bisnis fakultas ilmu administrasi universitas brawijaya malang 2015 —– proposal kegiatan magang pada pt platinum ceramics industry. Pada halaman ini juga terdapat nama panitia pelaksana dan kolam tanda tangan.
Berikut ini contoh teks eksplanasi singkat mengenai gerhana bulan lengkap dengan struktur nya.
123 Yogyakarta Dengan Hormat Bersama dengan. Agar permohonan tersebut dikabulkan ada saatnya kamu akan meminta atau memohon bantuan kepada orang lain dan biasanya harus mengajukan surat permohonan. Kepala bagian Personalia The Blitz Jl. Penutup Demikian proposal kegiatan ini kami buat semoga dapat menjadi gambaran atas rencana kegiatan Perayaan Hari Kemerdekaan ke-74 Republik Indonesia 17 Agustus 2019. Orang menulis surat pribadi karena adanya pergaulan sehari-hari. Ini Sebaran 8054 Kasus Baru.
 Source: mydigimag.rrd.com
Source: mydigimag.rrd.com
Latar BelakangTanggung Jawab Sosial Perusahaan atau biasa disebut Corporate Social Responsiblity CSR merupakan suatu upaya sungguh-sungguh dari perusahaan untuk meminimumkan dampak negatif dan memaksimumkan. Selamat pagi rekan-rekan gugus tugas Covid-19. Contoh kata pengantar singkat yang baik adalah terdiri dari pembuka isi dan penutup. Torimk universitas indonesia. Biasanya proposal penelitian berisi antara 2000 hingga 3500 kata 4-7 halaman.

Pada contoh teks berjudul Kiat Berwawancara Kerja pendahuluan yang dimaksud berupa pengertian wawancara dan manfaat bagi suatu perusahaan paragraf 1. Lubang got yang menampilkan karakter dari seri video game Pokemon di 20 kota dan kabupaten memberikan PokeLids ke semua kotamadya di prefektur tersebut. Puji syukur ke hadirat Tuhan saya masih bisa melihat rekan-rekan sekalian dalam keadaan sehat. Saya tahu rekan-rekan mungkin sudah bosan dengan kata-kata soal pandemi virus korona dan Covid-19. Penutup Interpretasi Disaat hujan ringan bersamaan dengan munculnya sinar matahari itu kita dapat melihat fenomena pelangi.

Proposal kegiatan magang oleh. Meskipun proposal sampai di perangkat klien dengan sangat cepat namun hal ini belum tentu menjamin proposal Anda akan segera dibaca. Penutup Interpretasi Disaat hujan ringan bersamaan dengan munculnya sinar matahari itu kita dapat melihat fenomena pelangi. Puji syukur ke hadirat Tuhan saya masih bisa melihat rekan-rekan sekalian dalam keadaan sehat. Penutup Got Bertema Pokemon Prefektur Miyagi akan memasang penutup.

REPUBLIKACOID ZURICH – Pemerintah Swiss merekomendasikan para pemilih agar pada referendum 7 Maret mendatang menolak usul larangan penutup wajah seperti burqa dan cadar yang dikenakan. Putri damayanti c 125030218113015 maela alfa fauza 125030218113019 siti ulfaniza a 125030218113036 rindy hartanti s 125030218113037 konsentrasi manajemen keuangan jurusan administrasi bisnis fakultas ilmu administrasi universitas brawijaya malang 2015 —– proposal kegiatan magang pada pt platinum ceramics industry. Saya tahu rekan-rekan mungkin sudah bosan dengan kata-kata soal pandemi virus korona dan Covid-19. Mengajukan proposal lewat email kini mulai dilakukan banyak instansi untuk menghemat waktu dan tenaga. PokeLids awalnya diperkenalkan di 15 kota besar dan kecil di sepanjang wilayah pesisir setelah monster Lapras ditunjuk sebagai maskot resmi prefektur pada 2019.
 Source: proposalkit.com
Source: proposalkit.com
Pada contoh teks berjudul Kiat Berwawancara Kerja pendahuluan yang dimaksud berupa pengertian wawancara dan manfaat bagi suatu perusahaan paragraf 1. 7 Contoh Kerangka Karangan Pengertian Fungsi Manfaat Kriteria Bentuk Pola Langkah Syarat Untuk pembahasan kali ini kami akan mengulas mengenai Kerangka Karangan yang dimana dalam hal ini meliputi contoh pengertian fungsi manfaat kriteria bentuk pola langkah dan syarat nah agar dapat lebih memahami dan dimengerti simak ulasan selengkapnya dibawah ini. Kepala bagian Personalia The Blitz Jl. Saya tahu rekan-rekan mungkin sudah bosan dengan kata-kata soal pandemi virus korona dan Covid-19. Berikut langkah membuat Kata pengantar yang singkat dan benar beserta contoh yang liputan6 rangkum untuk kamu yang sedang menulis skripsi tugas.
Source: proposalkit.com
Source: proposalkit.com
Penutup Demikian proposal kegiatan ini kami buat semoga dapat menjadi gambaran atas rencana kegiatan Perayaan Hari Kemerdekaan ke-74 Republik Indonesia 17 Agustus 2019. Namun haruslah dari arah yang berlawanan dengan kita. PENUTUP Demikianlah proposal ini kami buat sebagai kerangka acuan dalam melaksanakan kegiatan Kuliah Kerja Nyata KKN 2016 dengan harapan proposal ini dapat memberi gambaran secara umum tentang kegiatan kami dan dapat dijadikan sebagai bahan pertimbangan bagi pihak yang terkait untuk membantu serta bekerja sama demi suksesnya kegiatan ini. Surat pribadi juga disebut dengan surat prive. Ini contoh pesan WA yang beretika versi UI.
 Source: kompas.com
Source: kompas.com
7 Contoh Kerangka Karangan Pengertian Fungsi Manfaat Kriteria Bentuk Pola Langkah Syarat Untuk pembahasan kali ini kami akan mengulas mengenai Kerangka Karangan yang dimana dalam hal ini meliputi contoh pengertian fungsi manfaat kriteria bentuk pola langkah dan syarat nah agar dapat lebih memahami dan dimengerti simak ulasan selengkapnya dibawah ini. Penutup Got Bertema Pokemon Prefektur Miyagi akan memasang penutup. Judul KegiatanPelatihan manajemen corporate social responsibility CSR dan community development. Putri damayanti c 125030218113015 maela alfa fauza 125030218113019 siti ulfaniza a 125030218113036 rindy hartanti s 125030218113037 konsentrasi manajemen keuangan jurusan administrasi bisnis fakultas ilmu administrasi universitas brawijaya malang 2015 —– proposal kegiatan magang pada pt platinum ceramics industry. REPUBLIKACOID ZURICH – Pemerintah Swiss merekomendasikan para pemilih agar pada referendum 7 Maret mendatang menolak usul larangan penutup wajah seperti burqa dan cadar yang dikenakan.
 Source: kompas.com
Source: kompas.com
Lubang got yang menampilkan karakter dari seri video game Pokemon di 20 kota dan kabupaten memberikan PokeLids ke semua kotamadya di prefektur tersebut. Berikut ini contoh teks eksplanasi singkat mengenai gerhana bulan lengkap dengan struktur nya. Kepala bagian Personalia The Blitz Jl. Jadikan proposal Anda bintang di antara proposal lainnya dengan desain proposal kegiatan menarik yang tak biasa. Penutup Interpretasi Disaat hujan ringan bersamaan dengan munculnya sinar matahari itu kita dapat melihat fenomena pelangi.

123 Yogyakarta Dengan Hormat Bersama dengan. Namun saya tidak akan bosan untuk terus menyemangati rekan-rekan sekalian. Langkah-langkah berupa perincian petunjuk yang disarankan kepada pembaca terkait dengan topik yang ditentukan paragraf 2-9. Latar BelakangTanggung Jawab Sosial Perusahaan atau biasa disebut Corporate Social Responsiblity CSR merupakan suatu upaya sungguh-sungguh dari perusahaan untuk meminimumkan dampak negatif dan memaksimumkan. Contoh kata pengantar singkat yang baik adalah terdiri dari pembuka isi dan penutup.
 Source: proposalkit.com
Source: proposalkit.com
Ini Sebaran 8054 Kasus Baru. Agar permohonan tersebut dikabulkan ada saatnya kamu akan meminta atau memohon bantuan kepada orang lain dan biasanya harus mengajukan surat permohonan. Langkah-langkah berupa perincian petunjuk yang disarankan kepada pembaca terkait dengan topik yang ditentukan paragraf 2-9. Jika ketiga struktur penulisan ini kamu pahami maka kamu dapat membuat kata pengantar yang singkat dan jelas. Kepala bagian Personalia The Blitz Jl.
 Source: akseleran.co.id
Source: akseleran.co.id
Orang menulis surat pribadi karena adanya pergaulan sehari-hari. Ini contoh pesan WA yang beretika versi UI. Surat dinas adalah salah satu media komunikasi tertulis yang digunakan untuk menyampaikan suatu informasi tentang kedinasan dibuat oleh lembaga. Jika ketiga struktur penulisan ini kamu pahami maka kamu dapat membuat kata pengantar yang singkat dan jelas. Sub judul proposal adalah keterangan tentang isi dari proposal yang dibuat.

PENUTUP Demikianlah proposal ini kami buat sebagai kerangka acuan dalam melaksanakan kegiatan Kuliah Kerja Nyata KKN 2016 dengan harapan proposal ini dapat memberi gambaran secara umum tentang kegiatan kami dan dapat dijadikan sebagai bahan pertimbangan bagi pihak yang terkait untuk membantu serta bekerja sama demi suksesnya kegiatan ini. Lubang got yang menampilkan karakter dari seri video game Pokemon di 20 kota dan kabupaten memberikan PokeLids ke semua kotamadya di prefektur tersebut. Kepala bagian Personalia The Blitz Jl. Puji syukur ke hadirat Tuhan saya masih bisa melihat rekan-rekan sekalian dalam keadaan sehat. Namun saya tidak akan bosan untuk terus menyemangati rekan-rekan sekalian.
 Source: theconversation.com
Source: theconversation.com
Surat dinas adalah salah satu media komunikasi tertulis yang digunakan untuk menyampaikan suatu informasi tentang kedinasan dibuat oleh lembaga. Jika ketiga struktur penulisan ini kamu pahami maka kamu dapat membuat kata pengantar yang singkat dan jelas. Pada contoh teks berjudul Kiat Berwawancara Kerja pendahuluan yang dimaksud berupa pengertian wawancara dan manfaat bagi suatu perusahaan paragraf 1. Surat permohonan berisi tentang sebuah permintaan tentang sesuatu hal kepada pihak yang bersangkutan perseorangan badan atau lembaga organisasi perusahaan atau instansi dan lainnya. Mengajukan proposal lewat email kini mulai dilakukan banyak instansi untuk menghemat waktu dan tenaga.
 Source: theconversation.com
Source: theconversation.com
Pada contoh teks berjudul Kiat Berwawancara Kerja pendahuluan yang dimaksud berupa pengertian wawancara dan manfaat bagi suatu perusahaan paragraf 1. Penutup ialah bagian dari proposal yang didalamnya terdapat kata penutup proposal dan ucapan terima kasih. 123 Yogyakarta Dengan Hormat Bersama dengan. Namun haruslah dari arah yang berlawanan dengan kita. Pada halaman ini juga terdapat nama panitia pelaksana dan kolam tanda tangan.
 Source: figshare.com
Source: figshare.com
Ini Sebaran 8054 Kasus Baru. Biasanya proposal penelitian berisi antara 2000 hingga 3500 kata 4-7 halaman. Namun haruslah dari arah yang berlawanan dengan kita. Contoh dan Cara Membuat Surat Dinas Sumber Gambar. Secara teknis proposal penelitian tidak memiliki batas jumlah kata namun sebaiknya Anda mempertimbangkan pihak yang akan membaca proposal karena mereka harus membaca banyak proposal yang lain.
 Source: globalpartnership.org
Source: globalpartnership.org
Meskipun proposal sampai di perangkat klien dengan sangat cepat namun hal ini belum tentu menjamin proposal Anda akan segera dibaca. 123 Yogyakarta Dengan Hormat Bersama dengan. Biasanya proposal penelitian berisi antara 2000 hingga 3500 kata 4-7 halaman. REPUBLIKACOID ZURICH – Pemerintah Swiss merekomendasikan para pemilih agar pada referendum 7 Maret mendatang menolak usul larangan penutup wajah seperti burqa dan cadar yang dikenakan. Latar BelakangTanggung Jawab Sosial Perusahaan atau biasa disebut Corporate Social Responsiblity CSR merupakan suatu upaya sungguh-sungguh dari perusahaan untuk meminimumkan dampak negatif dan memaksimumkan.
 Source: researchgate.net
Source: researchgate.net
Penutup Demikian proposal kegiatan ini kami buat semoga dapat menjadi gambaran atas rencana kegiatan Perayaan Hari Kemerdekaan ke-74 Republik Indonesia 17 Agustus 2019. Pernyataan Umum Pembuka. Jika ketiga struktur penulisan ini kamu pahami maka kamu dapat membuat kata pengantar yang singkat dan jelas. Pada contoh teks berjudul Kiat Berwawancara Kerja pendahuluan yang dimaksud berupa pengertian wawancara dan manfaat bagi suatu perusahaan paragraf 1. Lubang got yang menampilkan karakter dari seri video game Pokemon di 20 kota dan kabupaten memberikan PokeLids ke semua kotamadya di prefektur tersebut.
 Source: cute766.info
Source: cute766.info
Judul KegiatanPelatihan manajemen corporate social responsibility CSR dan community development. Ini Sebaran 8054 Kasus Baru. Surat permohonan berisi tentang sebuah permintaan tentang sesuatu hal kepada pihak yang bersangkutan perseorangan badan atau lembaga organisasi perusahaan atau instansi dan lainnya. Akhiri pesan dengan mengucapkan terima kasih atau salam sebagai penutup. Pernyataan Umum Pembuka.
This site is an open community for users to share their favorite wallpapers on the internet, all images or pictures in this website are for personal wallpaper use only, it is stricly prohibited to use this wallpaper for commercial purposes, if you are the author and find this image is shared without your permission, please kindly raise a DMCA report to Us.
If you find this site convienient, please support us by sharing this posts to your favorite social media accounts like Facebook, Instagram and so on or you can also save this blog page with the title contoh penutup proposal covid 19 by using Ctrl + D for devices a laptop with a Windows operating system or Command + D for laptops with an Apple operating system. If you use a smartphone, you can also use the drawer menu of the browser you are using. Whether it’s a Windows, Mac, iOS or Android operating system, you will still be able to bookmark this website.





